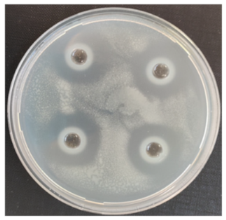
Fermentation 08 00716 i002
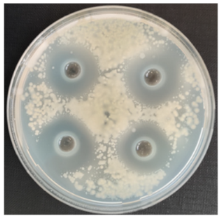
Fermentation 08 00716 i006

Abstract
In this study, water extracts from fermented (F), ultrasonicated (US), and enzyme-hydrolyzed (E) rice bran (RB) were evaluated against sixteen fungal plant stem and root-rot-associated pathogens. The effects of pre-treated RB additives on plant growth substrate (PGS) on bean and tomato seed germination, stem height and root length of seedlings, and chlorophyll concentration in plants were analyzed. The results showed that US-assisted pre-treatments did not affect protein content in RB, while 36 h semi-solid fermentation (SSF) reduced protein content by 10.3–14.8%. US initiated a 2.9- and 2-fold increase in total sugar and total phenolics (TPC) contents compared to the untreated RB (3.89 g/100 g dw and 0.61 mg GAE/g dw, respectively). Lactic acid (19.66–23.42 g/100 g dw), acetic acid (10.54–14.24 g/100g dw), propionic acid (0.40–1.72 g/100 g dw), phenolic compounds (0.82–1.04 mg GAE/g dw), among which phenolic acids, such as p-coumaric, cinnamic, sinapic, vanillic, and ferulic, were detected in the fermented RB. The RBF extracts showed the greatest growth-inhibition effect against soil-born plant pathogens, such as Fusarium, Pythium, Sclerotinia, Aspergillus, Pseudomonas, and Verticillium. Beans and tomatoes grown in RBUS+E- and RBF-supplemented PGS increased the germination rate (14–75%), root length (21–44%), and stem height (25–47%) compared to seedlings grown in PGS. The RB additives increased up to 44.6–48.8% of the chlorophyll content in both plants grown under greenhouse conditions. The results indicate that the biological potential of rice-milling waste as a plant-growth-promoting substrate component can be enhanced using solid-state fermentation with antimicrobial LABs and US processing.
1. Introduction
Large quantities of agro-industrial by-products are generated within the food production chain, and there is great potential for this biomass beyond its current main usage for the feed sector. Furthermore, growing conditions and the biological and nutrition potential of the soil are important criteria for improving crop yield and ensuring food safety [1]. The regulation of horticultural plant growth and the management of environmental stress are significant factors characterizing the productivity of cultivated plants.
As awareness regarding environmental sustainability and healthy food increases, there has been rapidly growing interest in the industry to provide innovative solutions for the management of cereal-based by-products based on a sustainable approach. In this case, the potential valorization of agro-industrial waste using environmentally friendly technologies would improve the sustainability of their processing.
Cereal-bran-based organic industrial by-products have potential as biofertilizers, as the essential nutrients they provide could offer a healthy supplement, improving biological activity and the growth of plants [2]. Rice bran (RB), as an excellent low-cost source of various components, such as carbohydrates, sugars, protein, and bioactive compounds (polyphenols and vitamins), may be an eligible substrate, containing the necessary nutrients for plants [3].
Many food-processing techniques, such as enzyme treatment and fermentation, have been investigated and applied to functionalize RB resources, improving their nutrition level [4,5]. Rice-milling by-products modified by enzymatic processing retain their nutrients, such that they can be used as functional food ingredients [5]. Higher protein, fibee, lipids, and mineral levels, as well as an increase in the availability of phenolic compounds, were observed after fermentation [6]. Fermentation of bran with appropriate lactic acid bacteria (LAB) increases the amount of essential, nonessential, and conditionally essential amino acids, affecting plant growth, formation, and the synthesis of chlorophyll [7]. Ultrasonic treatment of food waste is rapidly gaining popularity because it is an environmentally friendly and cost-effective process [8]. Ultrasound technology can modify rice-bran protein structures, producing functional peptides [9,10], and also physicochemical properties of dietary fiber and starch, changing their functional properties [8,11]. Therefore, ultrasound-assisted cellulase treatment is an effective strategy to functionalise brown rice nutritional components [12].
Plant diseases are a growing consequence of ongoing global warming. Soilborne fungal pathogens are one of the most predominant root-rot-causing agents, resulting in yield losses of agricultural and horticultural crops, which impacts greenhouse plant productivity and the quality of products. Root rot in tomato plants tends to be induced by Fusarium spp. and involves the infection of roots, leading to wilt and loss of 10–80% of yield [13,14]. Bean root rots are usually caused by Rhizoctonia spp., Fusarium spp., and Pythium spp. pathogens, which are long-lasting in infected soil. The pea root rot disease might be caused by a single pathogen or a combination of several pathogens, including Alternaria alternata, Fusarium oxysporum, F. avenaceum, F. solani, Pythium spp., Sclerotinia sclerotiorum, and Phytophthora spp. [15].
The capability of LAB to produce organic acids and antimicrobial compounds has made them essential not only in the preservation of foods but also in promoting significant positive changes in the health of plant foods [16]. Their metabolism throughout fermentation contributes to lowering some toxic and antinutritional factors and promoting bioavailable bioactive compounds [17,18]. This has also resulted in the categorization of LAB as generally regarded as safe (GRAS), posing no risks for applications in crop production [19].
Recently, LAB has been shown to be effective in the control of a wide variety of fungal and bacterial phytopathogens, as well as the alleviation of various abiotic stresses [16]. The extracts of fermented rice bran have shown antifungal potential against Aspergillus spp., Penicillium spp., and Fusarium spp., as well as antibacterial activity against Escherichia coli, Bacillus cereus, Salmonella typhimurium, and Pseudomonas aeruginosa [20,21]. However, to the best of our knowledge, the antifungal efficacy of the water extracts of rice bran on horticultural root-rot-causing bacteria remains under-investigated, although some reports have shown that rice bran is a potential source of antimicrobial compounds [4]. A better understanding of the symbiotic action between plants and LAB could be exploited to improve horticultural plant production.
In our study, we explored whether rice-milling waste could be used for the production of a new organic bio-product for horticultural plant-growth substrates via controlled microbial fermentation and ultrasound treatment. Furthermore, given its well-known spectrum of functionality, which includes its antimicrobial activity and potential for improved nutrition, its application may introduce new characteristics that result in a more stable and safe product. We focused on evaluating the growth-inhibition activity of rice bran (RB) functionalized by ultrasound and semi-solid fermentation (SSF) with antimicrobial LABs against phytopathogens associated with stem and root rot, and also analyzed the impact of functionalized RB additives on the seed germination and growth ability of horticultural plants, such as beans and tomatoes.
2. Materials and Methods
2.1. Materials
Rice-milling by-products (RB) were obtained from a local mill (Pasvalys, Lithuania). The raw material was fractionated by a laboratory sieve shaker (EFL 300, Endcotts Ltd., London, UK), and a protein-rich fraction of 500 µm particle size (moisture 12.19%, protein 15.42%, fat 11.14%, carbohydrate 61.25%) was selected for the experiment.
2.2. Lactic Acid Bacteria and Enzymes
Lactic acid bacteria (LAB) strains of Pediococcus acidilactici (DSM 20284) (Pa), Lactobacillus brevis (ATCC 367) (Lb), and L. uvarum (strain 8) (Lu), which indicate certain antifungal activity in rice bran media [21], were selected for the fermentation of RB material. Bacterial strains were stored at −80 °C in a Microbank system (Pro-Lab Diagnostics, Wirral, UK) and grown in a Man, Rogosa, and Sharpe (MRS) broth (CM 0359, Oxoid, Hampshire, UK) for 48 h at 30 °C before use. The initial concentration of bacterial cells was, on average, 1.4 × 109 of colony-forming units (CFU) per mL. Enzyme preparation (CeluStar XL, pH 6.0, 50 °C) from Dyadic International Inc. (Jupiter, FL, USA), containing mostly cellulase (20,000 CU/mL) and xylanase (15,000 XU/mL), as well as some protease (1500 PU/mL), was used for the hydrolysis of RB material.
2.3. Pre-Treatment of Rice Bran
The RB material before the planting experiment was pre-treated by ultrasound (US), semi-solid fermentation (SSF), or a combined procedure (US treatment following enzyme hydrolysis). For the ultrasonication, the sample (20 g) of the RB and distilled water were mixed with a ratio of 1:4. After that, the sample was placed in a plastic container (layer thickness 20 mm) and sonicated (850 kHz, 1.5 W/cm2) at 40 °C for 20 min in a ultrasonic bath (Meinhardt Ultraschalltechnik, Leipzig, Germany). The fermentation conditions were selected based on previous experiments [15,16]. For the fermentation experiment, the untreated RB sample (100 g) was mixed with sterile distilled water at a 1:4 ratio. After, the 2% (w/v) of pure LAB culture suspension was added in the untreated or ultrasonicated RB, and the samples were incubated for 36 h at 30 °C in containers tightly closed with foil. For enzymatic hydrolysis, 100 g RB sample was mixed with distilled water at a 1:4 ratio, and after adjusting the pH to 6 with 0.1 M HCl, the sample was incubated for 10 min at 50 °C temperature. Next, the Celustar XL preparation (400 CU/100 g) was added, and hydrolysis was performed for 60 min at 50 °C.
The RB samples were prepared in triplicate as follows: UN, untreated; US, ultrasonicated; US+E, ultrasonicated and hydrolyzed with Celustar XL; FPa, FLb, FLu, RB fermented with P. acidilactici (Pa), L. brevis (Lb), L. uvarum (Lu). Pre-treated RB samples were lyophilized and used as a supplement in the plant-growth substrate (PGS) in potting experiments and also in the transplantation soil mixture (TSM) for a greenhouse experiment.
2.4. Plants and Potting Procedure
For the plant growth experiments, Aura-variety bean (Phaseolus vulgaris L.) and Promyk-variety edible tomato (Solanum lycopersicum L.) seeds were selected. Plants were cultivated in plastic pots using 0.5 L of commercial PGS per pot. Seeds were sowed directly into a potting substrate without or with the addition of pre-treated RB at a concentration of 10% by weight of PGS. The experiment was carried out with 8 bean and 16 tomato plants for each test batch, respectively. Bean and tomato seedlings were moved to the TSM after 21 days of growth. The plants were grown in a greenhouse under controlled conditions (25 °C, 50–60% humidity) and irrigated with tap water.
2.5. Evaluation of Plant Growth Performance
The growth performance of the tomato and bean plants was determined according to Ranal and de Santana [22]. Germination rate, root length, and stem height were measured after every seven days during the 42-day growing period for beans and the 56-day period for tomatoes. The germination rate was expressed as the percentage of germinated seeds out of the total number of seeds used in the potting experiment. The height of the experimental seedlings was measured from the base reference point to the top of the seedling, and the length of the roots was measured as the length of the longest root at the end of the growing period in the greenhouse. Additionally, chlorophyll content in the plant tissue after the growing period was analyzed. The experiment was arranged with complete randomization, and all measurements were performed in triplicate.
2.6. Indicatory Microorganisms
Sixteen fungal plant-pathogenic strains (Table S1) from the Kaunas University of Technology (Kaunas, Lithuania) and Vytautas Magnus University Agriculture Academy (Kaunas distr., Lithuania) collections were used as indicatory microorganisms for the antimicrobial activity assay. Before the experiment, phytopathogens were cultured on the appropriate agar media at optimal temperatures for 14 days in the dark (Table S1). Fungal strains of Fusarium, Pythium, and Mucor were maintained on potato dextrose agar (PDA); strains of Sclerotinia, Cladosporium, Alternaria, Penicillium, and Aspergillus were maintained on Sabouraud dextrose agar (SDA), and Verticillium and Rhizopus strains were maintained on Mueller–Hinton agar (MHA). The fungal spore suspensions were prepared by vigorously shaking the slants of the conidia for 5 min with sterile peptone water (50 mL) and were then stored at 4 °C. The overnight bacterial suspensions were adjusted to 0.5 McFarland Standard with sterile peptone water. A spore concentration (106 spores/mL in half-strength) in the suspension was calculated using the Neubauer chamber cell-counting method.
2.7. Determination of Antifungal Activity
The growth-inhibition activity of untreated and pre-treated RB extracts against fungal plant pathogens was determined using the agar well diffusion method by measuring the inhibition zones that formed. The control extract was prepared by mixing untreated RB with distilled water (material to water ratio of 1:4, w/v) for 60 min and centrifuging at 4500× g for 15 min. The obtained extracts were filtered through sterile syringe filters (0.22 µm, PVDF). The Petri plates, filled with appropriate agar (25 mL), were overlaid with 100 μL of each fungal suspension, prepared as described in Section 2.6. Test extract sample (100 μL) was added to each well (6 mm in diameter) by punching into the cooled agar. The inhibition zone diameter was measured in mm after 48 h of incubation at 25 °C.
2.8. UFLC Analysis of Amino Acids
Amino acids were determined via ultrafast liquid chromatography (UFLC) with automated o-phthalaldehyde (OPA)/9-fluorenylmethyl chloroformate (FMOC). For the analysis, the RB samples were hydrolyzed with 6 N HCl at 110 °C for 24 h. The UFLC analysis of amino acids was performed according to Jukonyte et al. [21]. The amino acid standards (A9781 Sigma-Aldrich, Darmstadt, Germany) were analyzed at 0.5 μmol/mL concentration, except for L-cystine, at 0.25 μmol/mL in 0. odium citrate, pH 2.2. A five-level calibration set was used, covering a concentration range of 0.006–0.20 μmol/mL, except for alanine and cysteine, each covering a concentration range of 0.06–1.00 μmol/mL. All test samples were analyzed twice.
2.9. Analysis of Phenolic Compounds
Total phenolic compounds (TPC) in untreated and pre-treated RB was estimated by the Folin–Ciocalteu (FC) method [23]. Phenolic acids profile was determined via ultra-performance liquid chromatography/electron spray ionisation tandem quadrupole mass spectrometry (UPLC/ESI-MS/MS). The procedures of sample extract preparation and analysis are presented in Supplementary Materials (Methods S1 and S2).
2.10. UHPLC Analysis of Organic Acids
For the analysis of organic acids such as lactic, acetic, and propionic, the fermented samples (10 g) were mixed with 40 mL of distilled water and centrifuged (2800× g, 20 min). After filtration through a 0.22 μm PVDF filter, the supernatants were analyzed via reverse-phase ultra-high-performance liquid chromatography (UHPLC) with a Shimadzu LC-20AD Chromatography System with Diode Matrix Detector (Shimadzu Corp., Kyoto, Japan). The process used a hydrosphere C18 (150 × 4.6 I.D.) column (5 μm) and a mobile phase of 20 mM Na2HPO4 buffer (pH 2.5, H3PO4). It was performed at a rate of 1.0 mL/min, a temperature of 40 °C, duration of 30 min, a sample injection volume of 5 μL, and UV detection at 210 nm with a detection limit of 2 mg/L.
2.11. Chlorophyll Determination
Chlorophyll (Chl) content was measured in the plant leaves after 42 days of growing according to Costache et al. [24], with some modifications. For chlorophyll (Chl) determination, fresh plant material (100 mg) was homogenized (IKA Ultra-Turrax T-25, Staufen, Germany), and Chl extraction was performed using 100% acetone with a ratio of 1:50 (w/v) in the tightly closed tubes. After centrifugation at 3000× g for 10 min, the spectrophotometric measurements at wavelengths of 662 and 645 nm for Chl A and Chl B were performed. Chl contents were calculated according to the equations presented below [18].
Chl A = 11.75 A662 − 2.350 A645
Chl B = 18.61 A645 − 3.960 A662
2.12. Statistical Analysis
All chemical and microbiological analyses were performed in triplicate. The results are presented as mean values and standard deviations. The significant differences between means were assessed by analysis of variance (ANOVA) using the IBM SPSS Statistics 27.0 statistical package (SPSS Inc., Chicago, IL, USA). Data were analyzed by ANOVA, followed by the Fisher test, and were recognized as statistically significant at p < 0.05.
3. Results
3.1. Characterization of Rice Bran Material
Table 1 provides the contents of protein, saccharides, organic acids, and total phenolic compounds in the untreated rice bran (RB) and RB samples after different pre-treatments.
Table 1.
pH values, lactic acid bacteria (LAB) count (log10 CFU/g) contents of protein, sugars, and organic acids (g/100 g dw), and total phenolic compounds (TPC) (mg GAE/g dw) in untreated and functionalized rice bran (RB).
As can be seen from the table, the pH of the RB samples ranged from 6.48–6.70 in the control and RBUS samples to 3.68–3.97 in the RBF samples. According to the literature [25], pH value is one of the key factors affecting the growth of plants; the optimal soil conditions for germination of tomato seeds and plant growth are close to alkaline (pH 6.0–7.5), and bean plants prefer slightly acidic conditions (pH 5.8–6.5) for optimal growth and germination of their seed.
Applied US-assisted pre-treatments do have not a significant effect on protein content in RB samples, varying between 15.99 and 16.43 g/100 g. According to Nazari [26], ultrasound disrupts hydrogen bonds and hydrophobic interactions, thus leading to conformational changes in the secondary and tertiary structures.
Semi-solid fermentation (SSF) with selected LAB strains has reduced protein content by 10.3–14.8%. As confirmed by other researchers [27,28], in SSF processing, the protein fraction of rice bran plays a significant role as a nitrogen source for the growth of LAB. The decreases in protein levels have also been reported in fermented rice (8–19%) [29], attributed to the leaching of protein into liquid fraction or the action of proteolytic enzymes, which could have broken down the protein to lower fragments [30]. Other authors reporting an increase in proteins during the fermentation of cereals have ascribed this to protein synthesis during fermentation [31].
In the case of saccharides, pre-treated RB samples had significantly higher contents (p < 0.05) of total sugars, with the highest value in the RBUS+E sample (19.98 g/100 g dw), followed by the RBF samples (14.98–17.66 g/100 g dw). US treatment influenced a 2.9-fold increase in total sugar content compared to the control (3.89 g/100 g dw). However, carbohydrates, being one of the main energy sources for plant cells, play a fundamental role in seed development [32]; thus, US and US+E treatments would be more valuable in this regard.
The RBF samples contained 19.66–23.42 g/100 g dw total lactic acid with L/D = 0.64–1.15, depending on the LAB strain used. L-lactic acid concentrations varied between 8.40 g/100 g dw (P. acidilactici) and 12.53 g/100 g dw (L. brevis), and the content of D-lactic acid was determined to be between 9.23 g/100 g dw (L. uvarum) and 13.09 g/100 g dw (P. acidilactici). The contents of acetic acid and propionic acids in fermented RB were 10.54–14.24 and 0.40–1.72 g/100 g dw, respectively (Table 1).
Wang and co-authors [21] obtained 210 g/L L-lactic acid from the batch fermentation of defatted rice bran. Defatted rice bran was also used as a carbon source for D-lactic acid production by Tanaka et al. [33], who reported production of 28 g/L D-lactic acid at pH 5.0 by simultaneous saccharification and fermentation.
The analysis showed the contents of total phenolic compounds (TPC) varying from 0.61 up to 1.28 mg GAE/g dw (Table 1). Based on chromatographic analysis, PAs, such as p-coumaric, sinapic, vanillic, cinnamic, and ferulic, were detected in the RB samples (26.76–41.20 µg/g d.w.), depending on the pre-treatment method (Figure S2). The highest contents of ferulic (12.36–16.27 µg/g d.w.) and cinnamic acid (14.38–15.12 µg/g d.w.) were detected in the US-treated RB samples (Table S2).
Similar levels of TPC were detected by Shao et al. [34], indicating TPC contents for white rice between 14.6 and 33.4 mg GAE/100 g and for red rice between 66.8 and 422.2 mg GAE/100 g. According to these authors, the PA existed mainly in the bound form, among which, vanillic acid varied in a range of 24–54 µg/g only in black rice, p-coumaric acid varied at levels < 35 µg/g in red and black rice, and ferulic acid (40–179 µg/g dw), the most abundant bound phenolic acid, was observed at higher levels in black rice [34]. The increased phenolic acid content in RB is mainly caused due to the cleavage of compounds in conjunction with lignin.
In our study, US-assisted processing induced a 2-fold increase in the TPC content, while the SSF process increased the content of TPC by 33.8–70.1%, depending on the LAB used for fermentation. Similar results were reported by Iftikhar et al. [35], showing that ultrasound increased total phenolic and flavonoid contents, depending on process temperature, time, and water to solvent ratio, and also with Nisa et al. [36], where the content of phenolics was significantly improved during fermentation of RB with Lactobacillus lactis and L. plantarum strains. According to Abd Razak et al. [37], fermentation with Rhizopus oligosporus and Monascus purpureus enhanced the phenolic acid content in rice bran.
The authors suggest the novelty of US and SSF for enhancing the phytochemical content and increasing bioactive properties. Borges et al. [38] reported ferulic and gallic acids, indicating antimicrobial activity against food pathogens such as Pseudomonas aeruginosa, Escherichia coli, Staphylococcus aureus, and Listeria monocytogenes.
The phenolics present in plants, mainly including soluble and insoluble bound phenols [39], also can be partially released by the enzymatic degradation of the lignocelluloses [40] or degraded through the enzymatic pathway [41]. Liu et al. [42] reported an increase in the total phenolics and flavonoids by 46.24% and 79.13%, respectively, after complex enzyme hydrolysis of rice bran. A key role of phenolics is to act as plant-growth regulators [43], indicating antifungal and antibacterial properties [38,44].
3.2. The Impact of Rice Bran Pre-Treatments on Amino Acid Profile
The concentrations of essential amino acids (EAA) in RB samples ranged from 25.70/g 100 g to 32.58 g/100 g protein (Table 2). The contents of nonessential (NEAA) and conditionally essential amino acids (CEAA) were measured in a range of 17.89 to 45.57 g/100 g, and 19.63 to 33.18 g/100 g protein, respectively (Table 3).
Table 2.
Essential amino acids (EAA) (g/100 g protein) in rice bran (RB) after different pre-treatments.
Table 3.
Non-essential (NEAA) and conditionally essential amino acids (CEAA) (g/100 g protein) in rice bran (RB) after different pre-treatments.
US-assisted treatments of RB reduced the EAA, NEAA, and CEAA contents by 12.5, 29.8, and 16.2% on average, respectively, compared to RBUN, while fermentation lowered the EAA content by 17.8% on average and significantly (p < 0.05) increased the NEAA and CEAA contents (up to 68.4% and 36.6%, respectively), depending on LAB strain.
The results show that the most ASP and GLU was detected in L. brevis fermented RB, and the highest contents of LYS and MET were found in L. brevis and P. acidilactici-fermented RB samples. Moreover, the highest contents of PHE and THR were found in the control and US-treated RB samples.
Amino acids are important molecules in plants, regulating root and shoot formation and defending against stress [7]. GLU is considered as an effective nitrogen source for plant growth [45], and ASP has an essential role in nitrogen storage due to it having the highest nitrogen–carbon ratio [46]. PHE and THR are responsible for the resistance of plants to adverse growth conditions [47]. Adebiyi et al. [48] reported a 78% increase in amino acids during the fermentation of pearl millet. Pearl millet fermented at 24 h also had an increased protein content due to the loss of carbohydrates, while the same study reported a decrease in arginine, lysine, and glycine [49]. Changes in amino acid contents might be attributed to a combined effect of enzymatic proteolysis and acid-induced hydrolysis, implied by bacterial metabolism [50]. During lactic fermentation, LABs eventually break the polypeptide chains into smaller polypeptides and amino acids [51]. Extensive hydrolysis of protein produces amino acids that can increase the non-nitrogen content in fermented substrates.
3.3. Antifungal Activity of Pre-Treated Rice Bran Extracts
According to the microbiological analysis, the RBUN extract initiated antifungal activity against 11 pathogens with inhibition zones from 8 mm to 19 mm, showing the strongest effect against Rhizopus oryzae. The results of growth-inhibition activity analysis of US-treated and fermented RB extracts against plant root-rot-causing pathogens are presented in Table 4.
Table 4.
The diameters (in mm) of the inhibition zones formed by untreated and pre-treated rice bran extracts against plant pathogens.
US-treated RB extract showed inhibitory activity against 9 pathogens (inhibition zones 8–19 mm) with the strongest effect being against Mucor mucedo. RBUS+E extract was the most active against Verticillium wilt (inhibition zone 14 mm), and less active against Cladosporium herbarum (inhibition zone 11 mm) and Altenaria alternata (inhibition zone 9 mm). L. brevis- and L. uvarum-fermented RB extracts strongly inhibited the growth of 16 plant pathogens, while P. acidilactici-fermented RB extract showed antifungal effect against 12 pathogens.
The extract of 48 h L. brevis-fermented RB demonstrated the strongest growth-inhibition activity against Pythium volutum (inhibition zone 22–24 mm), followed by Fusarium avenaceum, F. graminearum, A. versicolor, and P. syringae (21–33 mm) and Sclerotinia sclerotiorum (19–22 mm). L. uvarum-fermented RB extract was mostly active against P. volutum, Verticillium wilt and R. oryzae (19–29 mm), P. syringae (17–26 mm), A. terreus (12–20 mm), and Fusarium spp. (10–27 mm), but did not show inhibitory activity against S. sclerotiorum. The extract of P. acidilactici-fermented RB was moderately active (8–20 mm) against 7 tested pathogenic strains, but had no inhibitory activity against P. volutum, S. sclerotiorum, or against 3 out of 4 tested Fusarium strains.
The improved microbial safety of fermented products was attributed to the organic acids produced by LABs [51]. The cultural filtrates of Lactobacillus plantarum 21B grown in wheat flour hydrolysate were reported to almost completely inhibit Eurotium repens, E. rubrum, Penicillium corylophilum, P. roqueforti, P. expansum, Aspergillus niger, A. flavus, and F. graminearum [52]. The fungicidic effect was attributed to the phenyllactic and 4-hydroxy-phenyllactic acids. Our previous study also showed that at low pH values, lactic acid may have a stronger inhibitory effect than acetic acid [21]. Corsetti et al. [53] have confirmed that acetic acid concentration is strongly related to the antifungal activity of L. sanfrancisco CB1, showing the most growth-inhibition activity against fungi of Fusarium, Penicillium, Aspergillus, and Monilia. A mixture of acetic, caproic, formic, propionic, butyric, and valeric acids, acting in a synergistic way, was responsible for the antifungal activity [53]. Generally, the antifungal effect of LAB was a result of synergistic interaction among various metabolites, including fatty acids, peptides, and organic acids [54], while the latter metabolites can be effective in controlling fungal growth and mycotoxin production in cereal-based substrates [55]. Our previous study [4] showed that the water extracts of RB that had been ultrasonicated and fermented with L. brevis had the highest antibacterial activity for inhibiting the growth of food pathogens, such as E. coli, S. typhimurium, P. aeruginosa, and Bacillus cereus.
3.4. The Effect of Rice Bran Additives on the Germination Rate and the Growth of Beans and Tomatoes
The effect of untreated, ultrasonicated, and fermented RB additives on the growth of horticulture plants, such as beans and tomatoes, was evaluated according to the germination rate, the frequency of stem formation, and the length of roots (Figure 1, Figure 2 and Figure 3).
Figure 1.
Effect of the rice bran (RB) additives to PGS on germination rate of bean and tomato seeds. Control, PGS; UN, untreated RB; US, ultrasonicated RB; US+E, ultrasonicated and enzyme-hydrolyzed RB; FPa, FLb, FLu, RB fermented with appropriate lactic acid bacteria strain. * significant at p < 0.05 compared to the controls.
Figure 2.
Influence of rice bran (RB) additives on bean (A) and tomato (B) root length. Control: PGS; PGS with RB: UN, untreated; US, ultrasonicated; US+E, ultrasonicated and enzyme-hydrolyzed; FPa, FLb, FLu, fermented with appropriate lactic acid bacteria strain. * significant at p < 0.05 compared to the controls.
Figure 3.
Influence of the rice bran (RB) additives on bean (A) and tomato (B) plant stem heights. Control: PGS; PGS with RB: UN, untreated; US, ultrasonicated; US+E, ultrasonicated and enzyme-hydrolyzed; FPa, FLb, FLu, fermented with appropriate lactic acid bacteria strain. * significant at p < 0.05 compared to the controls.
The results showed that PGS supplementation with RB had a significant (p < 0.05) positive effect on seed germination rate and growth performance for both tested plants (Figure 1).
In this case, the germination rate varied between 43 and 100% for beans, and between 88 and 100% for tomatoes, while this parameter for PGS (control sample) was significantly lower (25 and 86%, respectively). All RBF samples, containing higher CYS content among others (Table 2), improved the germination rate by 42–75% and 2–14% for both bean and tomato seeds, respectively.
In the case of root length, the effect of RB additives was fixed on the 21st day of growth for beans (Figure 2A) and on the 36th day for tomatoes (Figure 2B). Additional photos of plants and roots are presented in Supplementary Materials (Figures S2 and S3).
The RBF samples indicated the greatest effect on plant root formation (roots were longer by 28–44% for beans and 21–38% for tomatoes), while ultrasonicated RBUS improved the development of tomato roots slightly (by 8%) (Figure 2B). The combined treatment of RB (RBUS+E sample) showed a stronger positive effect on root formation for tomatoes (by 37%), but did not show a positive effect on bean roots (Figure 2A). The longest roots were measured for both plants grown in PGS supplemented with fermented with P. acidilactici RB (RBFPa sample), which contained the highest content of MET that is beneficial for root development.
The most positive effect on bean plant stem height was observed on the 21st day of growth for PGS supplemented with RBF additives (38–47% higher stems), followed by PGS supplemented with RBUS (18% higher stems), compared to beans grown in PGS and PGS+RBUN (an average stem height 12.16 cm) (Figure 3A). The most notable difference in tomato stem height was observed on the 28th day of the growth for PGS inoculated with RBFLb and RBUS+E (25 and 17% higher stems) compared to the PGS and PGS+RBUN substrates (an average height of 13.28 cm) (Figure 3B).
The use of additional organic materials to the substrate can improve plant physiological processes, such as the absorption of water, as well as nutrients [56]. For instance, the Aphanothece sp. bioproduct for tomatoes resulted in the maximum uptake (78.04–185.17%) of nitrogen, phosphorus, and potassium, and also significantly enhanced tomato root length (112.65%) [55]. In this study, the inoculation of PGS with fermented rice bran significantly (p < 0.05) improved the growth performance of tomato and bean seedlings (Figure 1 and Figure 2).
In the case of using rice bran for composting, Chanda et al. [56] showed that rice bran decomposed for 6 months under uncontrolled conditions in a glasshouse can be used for weed control and productivity increase for vegetable crops, such as tomatoes, in an organic farming system [56].
While composting and fermentation each have advantages and disadvantages, both biological processes are important for reducing the waste problem [57]. These processes make it possible to valorize organic materials and nutrients required for plants, thus supporting sustainable horticultural practices. However, composting is a process of uncontrolled decomposition of biodegradable materials under aerobic conditions, and fermentation is a degradation of biodegradable materials under anaerobic conditions, which can be controlled. In the case of biomass processing, fermentation compared to composting seems to be a more favorable solution for technological and economic reasons [57].
3.5. The Effect of Rice Bran Additives on Chlorophyll Formation in Plants
The results indicated a positive effect of RB additives on the formation of chlorophyll (Chl) in the tested plants (Table 5). In beans, 39.7 and 44.6 % higher levels of Chl A were observed in the case of RBUS and P. acidilactici- and L. uvarum-fermented RB samples, respectively, compared to PGS (17.14 mg/100 g). In tomatoes, 48.8 % higher levels of Chl A were observed in the case of RBUS+E and P. acidilactici- and L. brevis-fermented RB samples (37.1% on average) compared to the control (18.23 mg/100 g) (Table 5).
Table 5.
Chlorophyll (Chl) concentrations (mg/100 g) in bean and tomato leaves after 42 days of growth in PGS supplemented (10%, w/w) with functionalized rice bran (RB).
According to Mutale-Joan et al. [56], the occurrence of amino acids such as ALA, SER, PHE, and TYR in the substrate could positively affect chlorophyll concentration in horticultural plants such as tomatoes. The authors reported a 42% increase in Chl A content in tomato leaves after 35 days of treatment with Cyanobacter ellipsoidea extract compared with the control plant. Popko et al. [58] reported that the application of products based on amino acids influenced the increase of winter wheat yield by 5.4–11.0% when compared to the control group without biostimulant [58]. Similar results were obtained in the work of Colla et al. [59], who tested the effect of plant-derived protein hydrolysate containing amino acids and small peptides on the nitrogen uptake and growth stimulation of corn, tomato, and dwarf pea and showed that this hydrolysate enhanced nitrogen uptake based on extensive root growth and an increase in the nitrogen assimilation process, thus improving crop performance [60].
Similarly, our study indicates that organic acids and sugars, which are key components in plant nutrition, and phenolic acids, which act as plant bio-stimulants [60], were found in the highest levels in the RB samples pre-treated by US+E or SSF, demonstrating an appropriate plant-growth-promoting effect.
4. Conclusions
Our results show that US-treated and fermented rice-milling by-products contain valuable biological substances, inhibiting the growth of plant stem- and root-rot-causing microorganisms, while also demonstrating appropriate plant-growth-promoting properties. The increase in plant biomass was accompanied by increased chlorophyll synthesis, root formation, and seedling growth, confirming an increased ability to assimilate nutrients. The supplementation of PGS with ultrasound pre-treated or fermented RB significantly improved the germination rate (14–75%), root length (21–44%), and stem height (25–47%) of tomatoes and bean compared to seedlings grown in PGS.
Proteins of fermented RB contained lower amounts of essential amino acids (EAA), but significantly (p < 0.05) higher amounts of NEAA and CEAA compared to RBUN, thus strongly improving plant growth performance and chlorophyll formation. The use of SSF for pre-treatment of RB increased the growth-inhibition activity of their extracts against 16 of 17 tested plant fungal pathogens, thus leading to higher resistance of horticultural plants to fungal contamination. US-assisted treatments and fermentation significantly increased the contents of organic acids and phenolic compounds in the RB material.
The present study indicates that the biological potential of rice-milling waste can be increased using SSF with potentially antimicrobial LABs or combination of US processing with enzyme hydrolysis. We therefore recommend SSF with L. brevis as an effective method for the increment of bioactive components in RB material. However, more research is required to optimize the processing conditions, size of the inoculum, and starter culture age.
Supplementary Materials
The following supporting information can be downloaded at https://www.mdpi.com/article/10.3390/fermentation8120716/s1: Method S1, Sample preparation and analysis of total phenolic compounds; Method S2, UPLC-ESI-MS/MS analysis of phenolic acids; Method S3, Chemical Analysis; Table S1, Indicatory microorganisms, cultivation temperatures and media; Table S2, The phenolic acids detected in RB samples; Figure S1, Sample chromatograms of UPLC-ESI-MS/MS analysis of phenolic compounds; Figure S2, Bean plants and roots after 21 days of growth in a TMS under greenhouse conditions; Figure S3, Tomato plants after 28 days of growth in a TMS under greenhouse conditions.
Author Contributions
Methodology, investigation, writing—original draft, writing—review and editing, R.V.; methodology, data curation, N.B. and R.M.; methodology, resources, R.Z.; methodology, formal analysis, V.J.; writing—review and editing, resources, J.D.; conceptualization, data curation, writing—review and editing, supervision, D.Z. All authors have read and agreed to the published version of the manuscript.
Funding
This research received no external funding. The data presented in this article are a part of the PhD work of the first author.
Institutional Review Board Statement
Not applicable.
Informed Consent Statement
Not applicable.
Data Availability Statement
Not applicable.
Acknowledgments
The authors gratefully acknowledge the European Regional Development Fund and the Research Council of Lithuania (LMTLT) for supporting this research.
Conflicts of Interest
The authors declare no conflict of interest.
References
- Tilman, D.; Balzer, C.; Hill, J.; Befort, B.L. Global food demand and the sustainable intensification of agriculture. Proc. Natl. Acad. Sci. USA 2011, 108, 20260–20264. [Google Scholar] [CrossRef] [PubMed]
- Alauddin, M.; Mohsin, G.M.; Ali, A.H.M.Z.; Rahman, M.K. Interactive effects of rice bran compost and chemical fertilizers on macronutrients, oil and protein content in sunflower (Helianthus annuus L.). Int. J. Agric. Res. Innov. Technol. 2020, 10, 91–99. [Google Scholar] [CrossRef]
- Alauddin, M.; Jahidul, I.; Shirakawa, H.; Koseki, T.; Ardiansyah; Komai, M. Rice Bran as a Functional Food: An Overview of the Conversion of Rice Bran into a Superfood/Functional Food. In Superfood and Functional Food; Waisundara, V.Y., Shiomi, N., Eds.; Intech Open: London, UK, 2017; pp. 291–305. [Google Scholar]
- Vaitkeviciene, R.; Zadeike, D.; Gaizauskaite, Z.; Valentaviciute, K.; Marksa, M.; Mazdzieriene, R.; Bartkiene, E.; Lele, V.; Juodeikiene, G.; Jakstas, V. Functionalisation of rice bran assisted by ultrasonication and fermentation for the production of rice bran-lingonberry pulp-based probiotic nutraceutical. Int. J. Food Sci. Technol. 2022, 57, 1462–1472. [Google Scholar] [CrossRef]
- Vallabha, V.S.; Indira, T.N.; Lakshmi, A.J.; Radha, C.; Tiku, P.K. Enzymatic process of rice bran: A stabilized functional food with nutraceuticals and nutrients. J. Food Sci. Technol. 2015, 52, 8252–8259. [Google Scholar] [CrossRef] [PubMed]
- Ribeiro, A.C.; da Silva Graça, C.; Chiattoni, L.M.; Massarolo, K.C.; Duarte, F.A.; de Las Sallas Mellado, M.; de Souza Soares, L.A. Fermentation process in the availability of nutrients in rice bran. J. Microbiol. Biotechnol. 2017, 6, 45–52. [Google Scholar]
- Öpik, H.; Rolfe, S. Plant Growth Hormones. In The Physiology of Flowering Plants; Öpik, H., Rolfe, S., Willis, A., Eds.; Cambridge University Press: Cambridge, UK; London, UK, 2005; pp. 177–194. [Google Scholar]
- Zadeike, D.; Vaitkeviciene, R.; Degutyte, R.; Bendoraitiene, J.; Rukuiziene, Z.; Cernauskas, D.; Svazas, M.; Juodeikiene, G. A comparative study on the structural and functional properties of water-soluble and alkali-soluble dietary fibres from rice bran after hot-water, ultrasound, cellulase hydrolysis and combined pre-treatments. Int. Food Sci. Technol. 2022, 57, 1137–1149. [Google Scholar] [CrossRef]
- Wang, T.; Chen, X.; Wang, W.; Wang, L.; Jiang, L.; Yu, D.; Xie, F. Effect of ultrasound on the properties of rice bran protein and its chlorogenic acid complex. Ultrason. Sonochem. 2021, 79, 105758. [Google Scholar] [CrossRef]
- Digaitiene, A.; Hansen, A.S.; Juodeikiene, G.; Eidukonyte, D.; Josephsen, J. Lactic acid bacteria isolated from rye sourdoughs produce bacteriocin-like inhibitory substances active against Bacillus subtilis and fungi. J. Appl. Microbiol. 2012, 112, 732–742. [Google Scholar] [CrossRef]
- Vaitkeviciene, R.; Bendoraitiene, J.; Degutyte, R.; Svazas, M.; Zadeike, D. Optimization of the sustainable production of resistant starch in rice bran and evaluation of its physicochemical and technological properties. Polymers 2022, 14, 3662. [Google Scholar] [CrossRef]
- Li, H.; Xu, M.; Yao, X.; Wen, Y.; Lu, S.; Wang, J.; Sun, B. The promoted hydrolysis effect of cellulase with ultrasound treatment is reflected on the sonicated rather than native brown rice. Ultrason. Sonochem. 2022, 83, 105920. [Google Scholar] [CrossRef]
- Singh, V.K.; Singh, A.K.; Kumar, A. Disease management of tomato through PGPB: Current trends and future perspective. 3 Biotech 2017, 7, 255. [Google Scholar] [CrossRef] [PubMed]
- Singh, V.K.; Singh, H.B.; Upadhyay, R.S. Role of fusaric acid in the development of ‘Fusarium wilt’ symptoms in tomato: Physiological, biochemical and proteomic perspectives. Plant Physiol. Biochem. 2017, 118, 320–332. [Google Scholar] [CrossRef] [PubMed]
- Taheri, A.E.; Chatterton, S.; Foroud, N.A.; Gossen, B.D.; McLaren, D.L. Identification and community dynamics of fungi associated with root, crown, and foot rot of field pea in western. Can. Eur. J. Plant Pathol. 2017, 147, 489–500. [Google Scholar] [CrossRef]
- Lamont, J.R.; Wilkins, O.; Bywater-Ekegärd, M.; Smith, D.L. From yogurt to yield: Potential applications of lactic acid bacteria in plant production. Soil Biol. Biochem. 2017, 111, 1–9. [Google Scholar] [CrossRef]
- Garsa, A.K.; Kumariya, R.; Sood, S.K.; Kumar, A.; Kapila, S. Bacteriocin production and different strategies for their recovery and purification. Probiotics Antimicrob. Proteins 2014, 6, 47–58. [Google Scholar] [CrossRef]
- Marco, M.L.; Heeney, D.; Binda, S.; Cifelli, C.J.; Cotter, P.D.; Foligné, B.; Gänzle, M.; Kort, R.; Pasin, G.; Pihlanto, A.; et al. Health benefits of fermented foods: Microbiota and beyond. Curr. Opin. Biotechnol. 2017, 44, 94–102. [Google Scholar] [CrossRef]
- Lutz, M.P.; Michel, V.; Martinez, C.; Camps, C. Lactic acid bacteria as biocontrol agents of soil-borne pathogens. IOBC-WPRS Bull. 2012, 78, 285–288. [Google Scholar]
- Vaitkevičienė, R.; Žadeikė, D.; Bartkienė, E.; Krunglevičiūtė, V.; Baliukoniene, V.; Supronienė, S.; Juodeikienė, G. The use of rice polish medium for the evaluation of antifungal activity of lactic acid bacteria. Zemdirb. Agric. 2019, 106, 59–64. [Google Scholar] [CrossRef]
- Jukonyte, R.; Zadeike, D.; Bartkiene, E.; Lele, V.; Juodeikiene, G.; Cernauskas, D.; Suproniene, S. A potential of brown rice polish as a substrate for the lactic acid and bioactive compounds production by the lactic acid bacteria newly isolated from cereal-based fermented products. LWT Food Sci. Technol. 2018, 97, 323–331. [Google Scholar] [CrossRef]
- Ranal, M.A.; de Santana, D.G. How and why to measure the germination process? Braz. J. Bot. 2006, 29, 1–11. [Google Scholar] [CrossRef]
- Singleton, V.L.; Orthofer, R.; Lamuela-Raventós, R.M. Analysis of total phenols and other oxidation substrates and antioxidants by means of folin-ciocalteu reagent. Methods Enzymol. 1999, 299, 152–178. [Google Scholar]
- Costache, M.A.; Campeanu, G.; Neata, G. Studies concerning the extraction of chlorophyll and total carotenoids from vegetables. Rom. Biotechnol. Lett. 2012, 17, 7702–7708. [Google Scholar]
- Jarboui, R.; Dhouib, B.; Ammar, E. Effect of food waste compost (FWC) and its non-aerated fermented extract (NFCE) on seeds germination and plant growth. Open J. Soil Sci. 2021, 11, 122–138. [Google Scholar] [CrossRef]
- Nazari, B.; Mohammadifar, M.A.; Shojaee-Aliabadi, S.; Feizollahi, E.; Mirmoghtadaie, L. Effect of ultrasound treatments on functional properties and structure of millet protein concentrate. Ultrason. Sonochem. 2018, 41, 382–388. [Google Scholar] [CrossRef] [PubMed]
- Taniguchi, M.; Hoshina, M.; Tanabe, S.; Higuchi, Y.; Sakai, K.; Ohtsubo, S.; Hoshino, K.; Tanaka, T. Production of L-lactic acid by simultaneous saccharification and fermentation using unsterilized defatted rice bran as a carbon source and nutrient components. Food Sci. Technol. Res. 2005, 11, 400–406. [Google Scholar] [CrossRef][Green Version]
- Wang, Y.; Yang, Z.; Qin, P.; Tan, T. Fermentative L-(+)-lactic acid production from defatted rice bran. RSC Adv. 2014, 4, 8907–8913. [Google Scholar] [CrossRef]
- Nnam, N.M.; Obiakor, P.N. Effect of fermentation on the nutrient and antinutrient composition of baobab (Adansonia digitata) seeds and rice (Oryza sativa) grains. Ecol. Food Nutr. 2003, 42, 265–277. [Google Scholar] [CrossRef]
- Oladeji, B.S.; Irinkoyenikan, O.A.; Akanbi, C.T.; Gbadamosi, S.O. Effect of fermentation on the physicochemical properties, pasting profile and sensory scores of normal endosperm maize and quality protein maize flours. Int. Food Res. J. 2018, 25, 1100–1108. [Google Scholar]
- dos Oliveira, M.S.; Feddern, V.; Kupski, L.; Cipolatti, E.P.; Badiale-Furlong, E.; de Souza-Soares, L.A. Physico-chemical characterization of fermented rice bran biomass. CyTA-J. Food 2010, 8, 229–236. [Google Scholar] [CrossRef]
- Aguirre, M.; Kiegle, E.; Leo, G.; Ezquer, I. Carbohydrate reserves and seed development: An overview. Plant Reprod. 2018, 3, 263–290. [Google Scholar] [CrossRef]
- Tanaka, T.; Hoshina, M.; Tanabe, S.; Sakai, K.; Ohtsubo, S.; Taniguchi, M. Production of D-lactic acid from defatted rice bran by simultaneous saccharification and fermentation. Bioresour. Technol. 2006, 97, 211–217. [Google Scholar] [CrossRef] [PubMed]
- Shao, Y.; Xu, F.; Sun, X.; Bao, J.; Beta, T. Phenolic acids, anthocyanins, and antioxidant capacity in rice (Oryza sativa L.) grains at four stages of development after flowering. Food Chem. 2014, 143, 90–96. [Google Scholar] [CrossRef] [PubMed]
- Iftikhar, M.; Zhang, H.; Iftikhar, A.; Raza, A.; Begum, N.; Tahamina, A.; Syed, H.; Khan, M.; Wang, J. Study on optimization of ultrasonic assisted extraction of phenolic compounds from rye bran. LWT Food Sci. Technol. 2020, 134, 110243. [Google Scholar] [CrossRef]
- Nisa, K.; Rosyida, V.; Nurhayati, S.; Indrianingsih, A.; Darsih, C.; Apriyana, W. Total phenolic contents and antioxidant activity of rice bran fermented with lactic acid bacteria. IOP Conf. Ser. Earth Environ. Sci. 2019, 251, 0120202019. [Google Scholar] [CrossRef]
- Razak, D.L.A.; Rashid, N.Y.A.; Jamaluddin, A.; Sharifudin, S.A.; Long, K. Enhancement of phenolic acid content and antioxidant activity of rice bran fermented with Rhizopus oligosporus and Monascus purpureus. Biocatal. Agric. Biotechnol. 2015, 4, 33–38. [Google Scholar] [CrossRef]
- Borges, A.; Ferreira, C.; Saavedra, M.J.; Simões, M. Antibacterial activity and mode of action of ferulic and gallic acids against pathogenic bacteria. Microb. Drug Resist. 2013, 19, 256–265. [Google Scholar] [CrossRef]
- Padayachee, A.; Netzel, G.; Netzel, M.; Day, L.; Zabaras, D.; Mikkelsen, D.; Gidley, M. Binding of polyphenols to plant cell wall analogues-part 2: Phenolic acids. Food Chem. 2012, 135, 2287–2292. [Google Scholar] [CrossRef]
- Coniglio, R.O.; Díaz, G.V.; Barua, R.C.; Albertó, E.; Zapata, P.D. Enzyme-assisted extraction of phenolic compounds and proteins from sugarcane bagasse using a low-cost cocktail from Auricularia fuscosuccinea. Int. J. Food Sci. Technol. 2022, 57, 1114–1121. [Google Scholar] [CrossRef]
- de la Rosa, L.A.; Moreno-Escamilla, J.O.; Rodrigo-García, J.; Alvarez-Parrilla, E. Phenolic Compounds. In Postharvest Physiology and Biochemistry of Fruits and Vegetables; Yahia, E.M., Ed.; Woodhead Publishing: London, UK, 2019; pp. 253–271. [Google Scholar]
- Liu, L.; Wen, W.; Zhang, R.; Wei, Z.; Deng, Y.; Xiao, J.; Zhang, M. Complex enzyme hydrolysis releases antioxidative phenolics from rice bran. Food Chem. 2017, 214, 1–8. [Google Scholar] [CrossRef]
- Lattanzio, V.; Veronica, M.; Lattanzio, T.; Cardinali, A. Role of Phenolics in the Resistance Mechanisms of Plants Against Fungal Pathogens and Insects. In Phytochemistry: Advances in Research; Imperato, F., Ed.; Research Signpost: Kerala, India, 2006; pp. 23–67. [Google Scholar]
- Li, Z.J.; Liu, M.; Dawuti, G.; Dou, Q.; Ma, Y.; Liu, H.G.; Aibai, S. Antifungal activity of gallic acid in vitro and in vivo. Phytother. Res. 2017, 19, 1039–1045. [Google Scholar] [CrossRef]
- Kan, C.-C.; Chung, T.-Y.; Juo, Y.-A.; Hsieh, M.-H. Glutamine rapidly induces the expression of key transcription factor genes involved in nitrogen and stress responses in rice roots. BMC Genom. 2015, 16, 731. [Google Scholar] [CrossRef]
- Gaufichon, L.; Reisdorf-Cren, M.; Rothstein, S.J.; Chardon, F.; Suzuki, A. Biological functions of asparagine synthetase in plants. Plant Sci. 2010, 179, 141–153. [Google Scholar] [CrossRef]
- Killiny, N.; Hijaz, F. Amino acids implicated in plant defense are higher in Candidatus Liberibacter asiaticus-tolerant citrus varieties. Plant Signal. Behav. 2016, 11, 1171449. [Google Scholar] [CrossRef]
- Adebiyi, J.A.; Obadina, A.O.; Adebo, O.A.; Kayitesi, E. Comparison of nutritional quality and sensory acceptability of biscuits obtained from native, fermented, and malted pearl millet (Pennisetum glaucum) flour. Food Chem. 2017, 233, 210–217. [Google Scholar] [CrossRef]
- Osman, M.A. Effect of traditional fermentation process on the nutrient and antinutrient contents of pearl millet during preparation of Lohoh. J. Saudi Soc. Agric. Sci. 2011, 10, 1–6. [Google Scholar] [CrossRef]
- Meinlschmidt, P.; Ueberham, E.; Lehmann, J.; Schweiggert-Weisz, U.; Eisner, P. Immunoreactivity, sensory and physicochemical properties of fermented soy protein isolate. Food Chem. 2016, 205, 229–238. [Google Scholar] [CrossRef]
- Aguirre, L.; Garro, M.S.; de Giori, G.S. Enzymatic hydrolysis of soybean protein using lactic acid bacteria. Food Chem. 2008, 111, 976–982. [Google Scholar] [CrossRef]
- Lavermicocca, P.; Valerio, F.; Evidente, A.; Lazzaroni, S.; Corsetti, A.; Gobbeti, M. Purifcation and characterization of novel antifungal compounds from the sourdough Lactobacillus plantarum Strain 21B. Appl. Environ. Microbiol. 2000, 66, 4084–4090. [Google Scholar] [CrossRef]
- Corsetti, A.; Gobbetti, M.; Rossi, J.; Damiani, P. Antimould activity of sourdough lactic acid bacteria: Identification of a mixture of organic acids produced by Lactobacillus sanfrancisco CB1. Appl. Microbiol. Biotechnol. 1998, 50, 253–256. [Google Scholar] [CrossRef]
- Ogunremi, O.R.; Banwo, K.; Sanni, A.I. Starter-culture to improve the quality of cereal-based fermented foods: Trends in selection and application. Curr. Opin. Food Sci. 2017, 13, 38–43. [Google Scholar] [CrossRef]
- Zadeike, D.; Vaitkeviciene, R.; Bartkevics, V.; Bogdanova, E.; Bartkiene, E.; Lele, V.; Juodeikiene, G.; Cernauskas, D.; Valatkeviciene, Z. The expedient application of microbial fermentation after whole-wheat milling and fractionation to mitigate mycotoxins in wheat-based products. LWT Food Sci. Technol. 2021, 137, 110440. [Google Scholar] [CrossRef]
- Mutale-Joan, C.; Redouane, B.; Najib, E.; Yassine, K.; Lyamlouli, K.; Laila, S.; Zeroual, Y.; Hicham, A. Screening of microalgae liquid extracts for their bio stimulant properties on plant growth, nutrient uptake and metabolite profile of Solanum lycopersicum L. Sci. Rep. 2020, 10, 2820. [Google Scholar] [CrossRef] [PubMed]
- Jędrczak, A. Composting and fermentation of biowaste—Advantages and disadvantages of processes. Civ. Environ. Eng. Reports 2018, 28, 71–87. [Google Scholar] [CrossRef]
- Popko, M.; Michalak, I.; Wilk, R.; Gramza, M.; Chojnacka, K.; Górecki, H. Effect of the new plant growth biostimulants based on amino acids on yield and grain quality of winter wheat. Molecules 2018, 23, 470. [Google Scholar] [CrossRef]
- Colla, G.; Rouphael, Y.; Canaguier, R.; Svecova, E.; Cardarelli, M. Biostimulant action of a plant-derived protein hydrolysate produced through enzymatic hydrolysis. Front. Plant Sci. 2014, 5, 448. [Google Scholar] [CrossRef]
- Kisiriko, M.; Anastasiadi, M.; Terry, L.A.; Yasri, A.; Beale, M.H.; Ward, J.L. Phenolics from medicinal and aromatic plants: Characterisation and potential as biostimulants and bioprotectants. Molecules 2021, 26, 6343. [Google Scholar] [CrossRef]
Publisher’s Note: MDPI stays neutral with regard to jurisdictional claims in published maps and institutional affiliations. |
© 2022 by the authors. Licensee MDPI, Basel, Switzerland. This article is an open access article distributed under the terms and conditions of the Creative Commons Attribution (CC BY) license (https://creativecommons.org/licenses/by/4.0/).